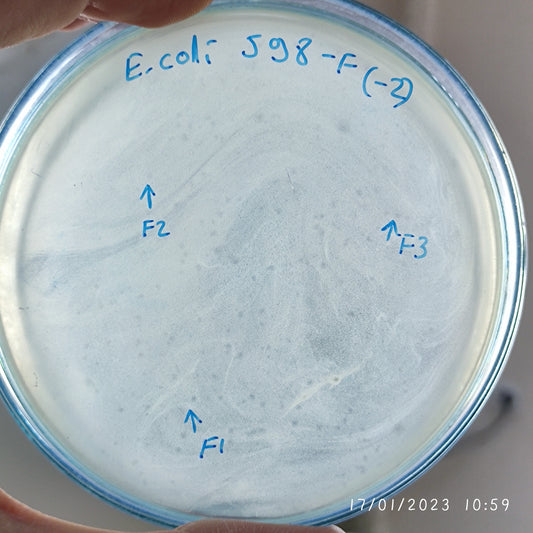
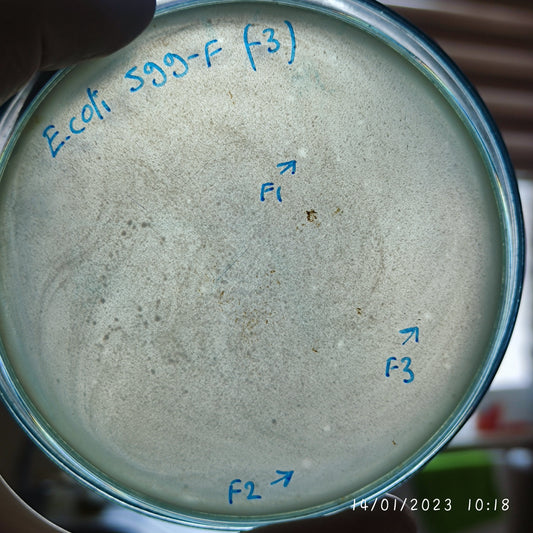
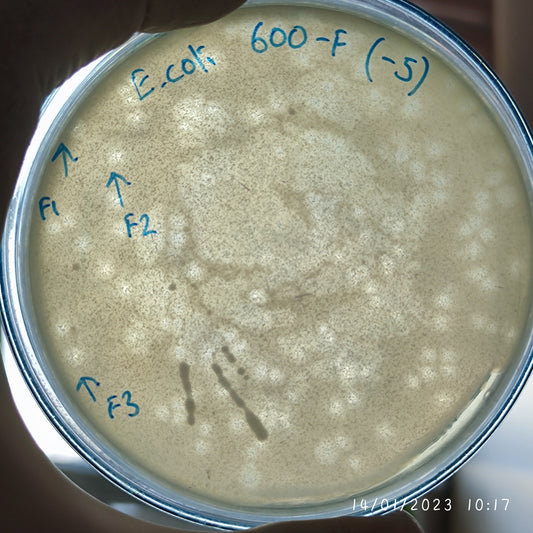
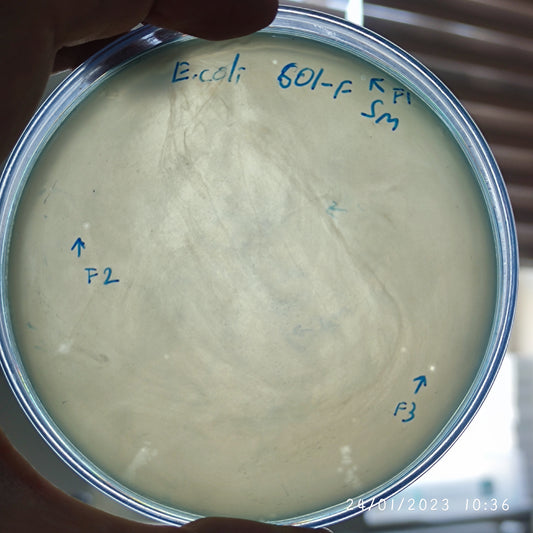
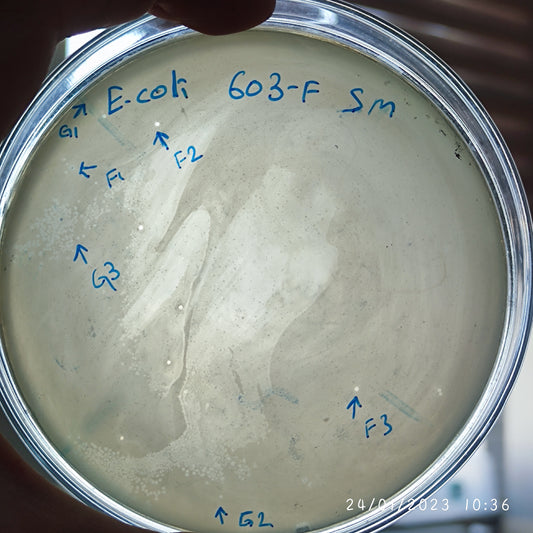
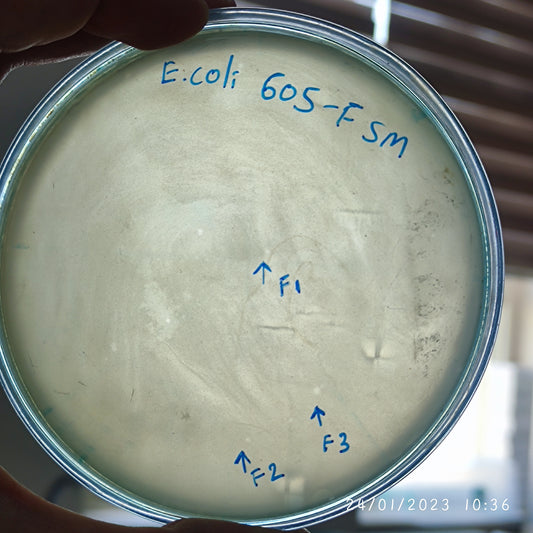
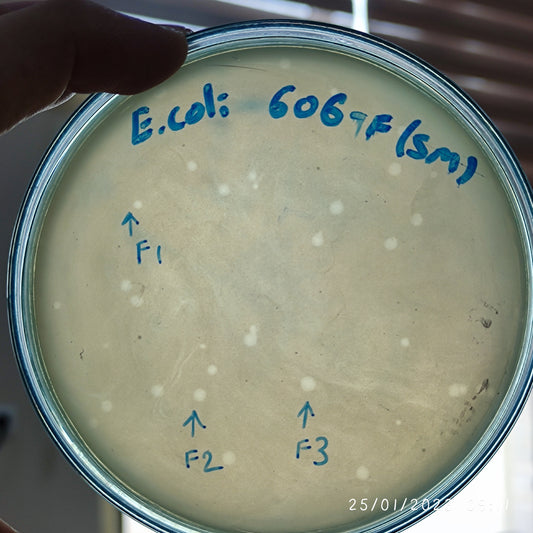
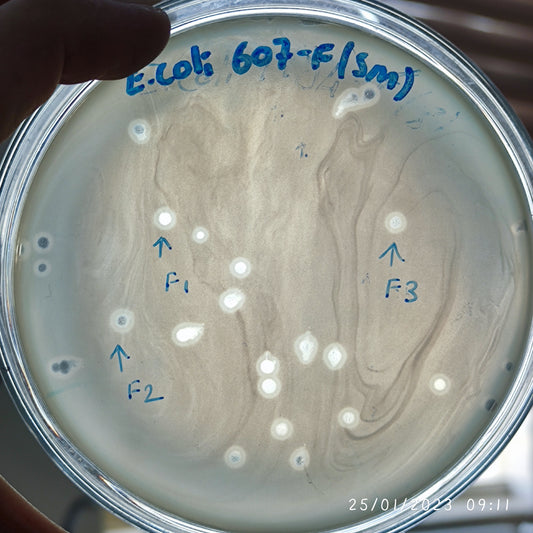
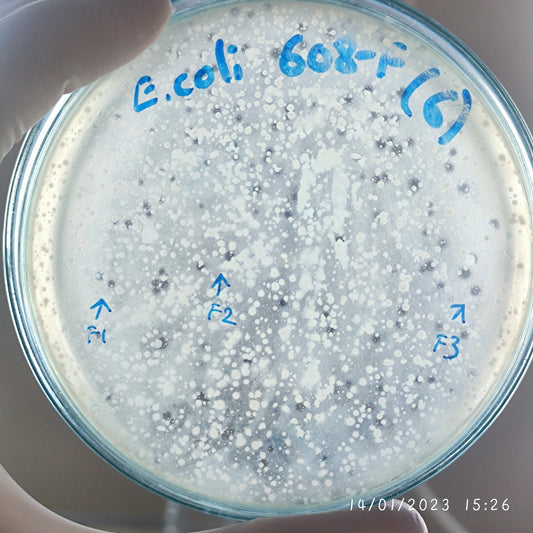
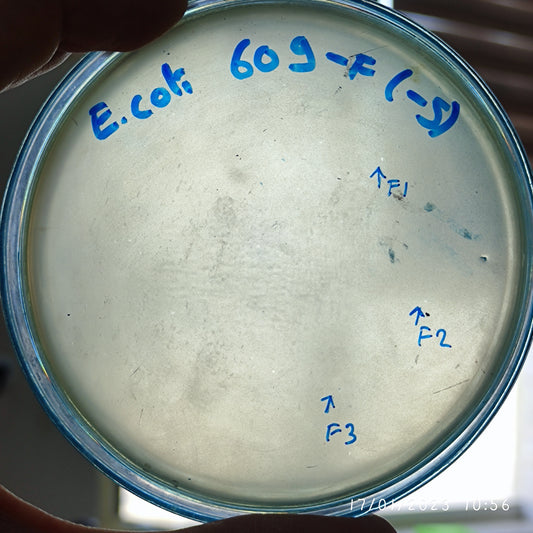
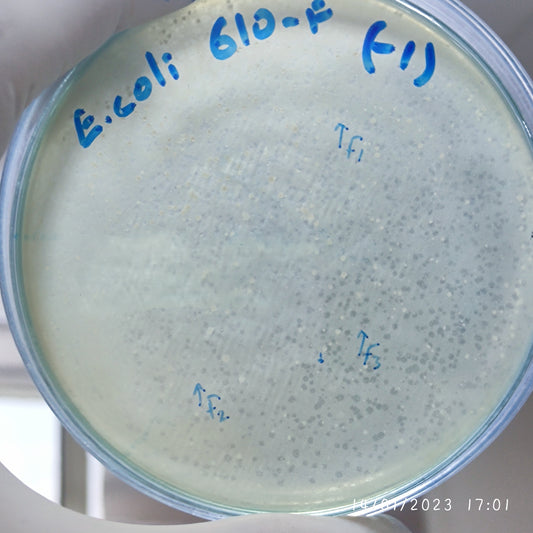
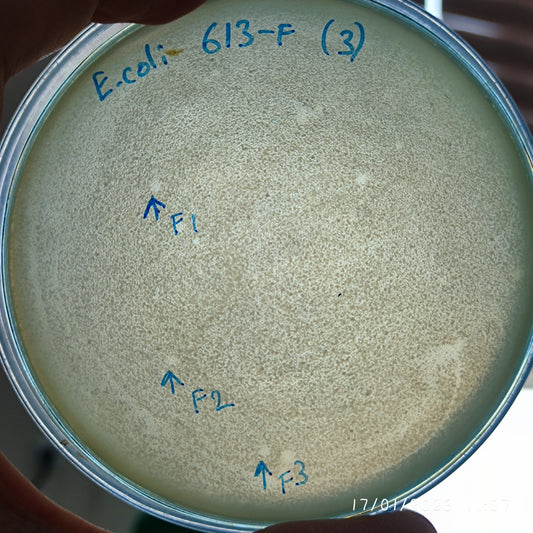

-
Escherichia coli bacteriophage 100598F
Regular price $500.00 USDRegular priceUnit price per -
Escherichia coli bacteriophage 100599F
Regular price $500.00 USDRegular priceUnit price per -
Escherichia coli bacteriophage 100600F
Regular price $500.00 USDRegular priceUnit price per -
Escherichia coli bacteriophage 100601F
Regular price $750.00 USDRegular priceUnit price per -
Escherichia coli bacteriophage 100602F
Regular price $500.00 USDRegular priceUnit price per -
Escherichia coli bacteriophage 100603F
Regular price $750.00 USDRegular priceUnit price per -
Escherichia coli bacteriophage 100603G
Regular price $750.00 USDRegular priceUnit price per -
Escherichia coli bacteriophage 100604F
Regular price $500.00 USDRegular priceUnit price per -
Escherichia coli bacteriophage 100605F
Regular price $700.00 USDRegular priceUnit price per -
Escherichia coli bacteriophage 100606F
Regular price $750.00 USDRegular priceUnit price per -
Escherichia coli bacteriophage 100607F
Regular price $800.00 USDRegular priceUnit price per -
Escherichia coli bacteriophage 100608F
Regular price $500.00 USDRegular priceUnit price per -
Escherichia coli bacteriophage 100609F
Regular price $550.00 USDRegular priceUnit price per -
Escherichia coli bacteriophage 100610F
Regular price $500.00 USDRegular priceUnit price per -
Escherichia coli bacteriophage 100613F
Regular price $500.00 USDRegular priceUnit price per -
Escherichia coli bacteriophage 100614F
Regular price $650.00 USDRegular priceUnit price per